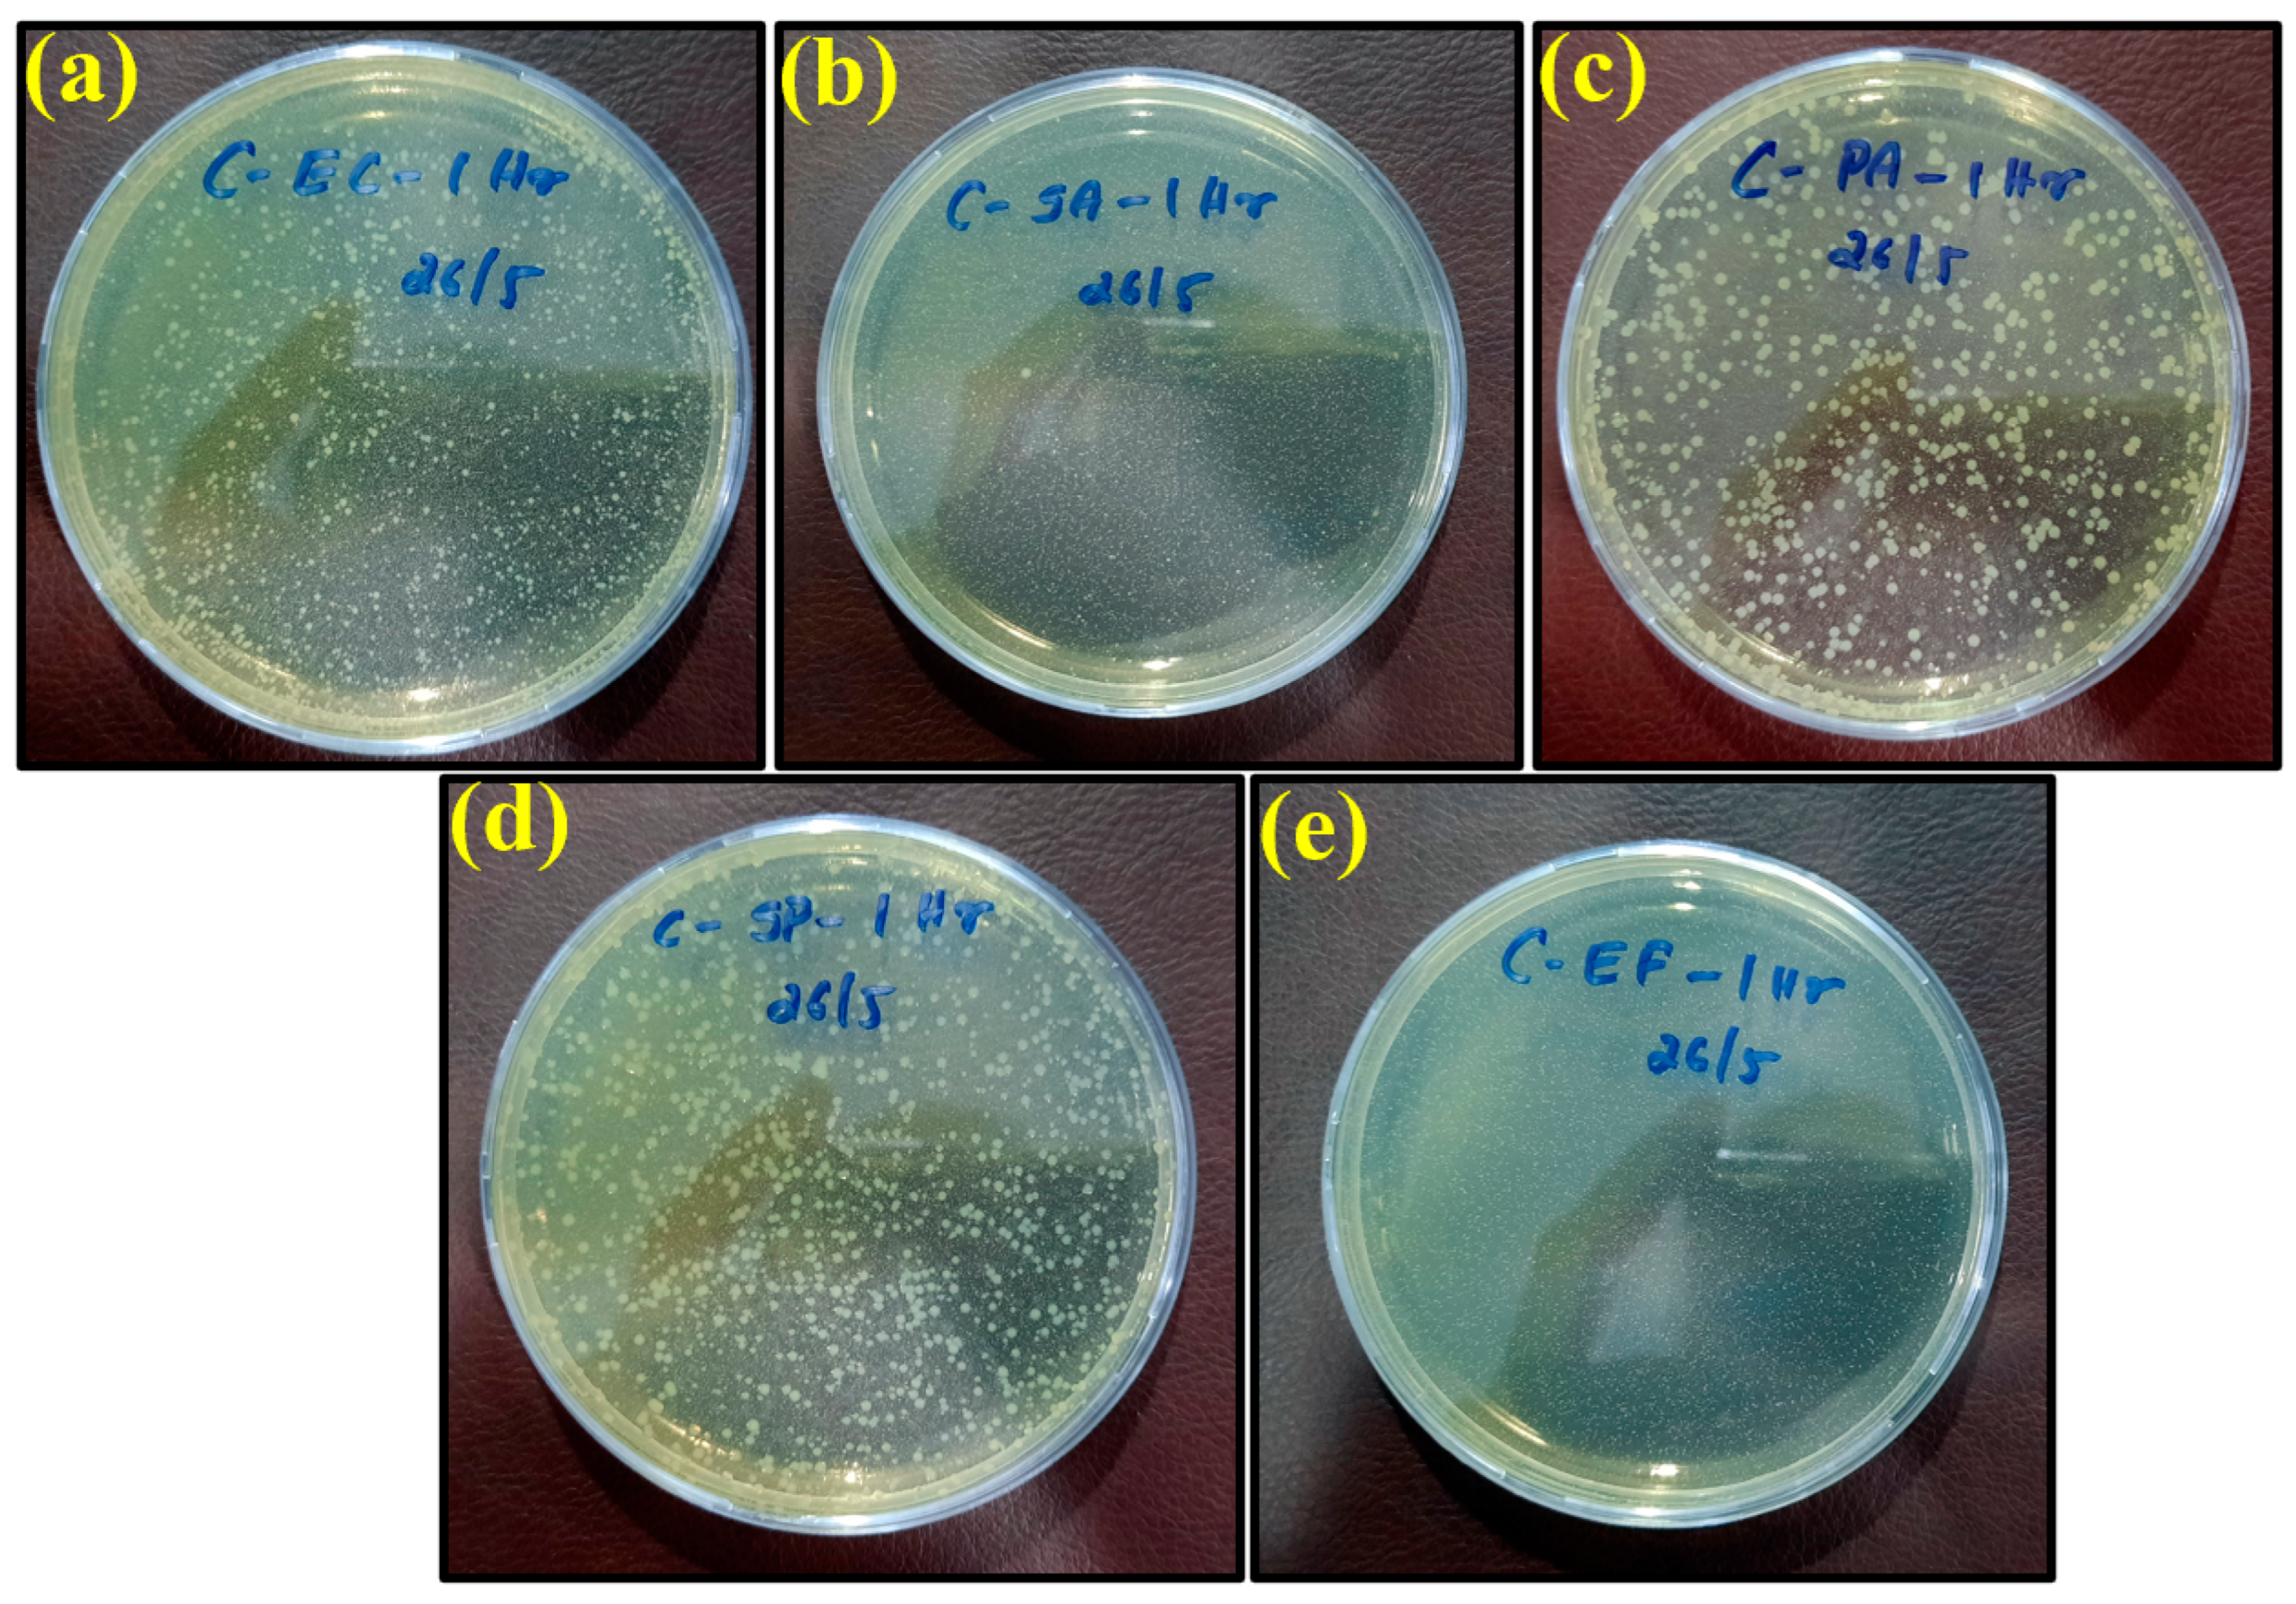
Ijms 23 11235 g006

Comparative Experimental Investigation of Biodegradable Antimicrobial Polymer-Based Composite Produced by 3D Printing Technology Enriched with Metallic Particles
Abstract
1. Introduction
2. Results and Discussion
2.1. Bacterial Elimination and Evaluation
2.2. Comparison with Other Materials
3. Materials and Methods
- Sample 1: Copper/PLA
- Sample 2: Aluminum 6061/PLA
- Sample 3: Bronze/PLA
- Sample 4: Stainless steel 17-4 /PLA
Antimicrobial Testing and Standards
4. Conclusions
Author Contributions
Funding
Institutional Review Board Statement
Informed Consent Statement
Data Availability Statement
Conflicts of Interest
References
- Corrêa, A.C.; de Santi, C.R.; Manrich, S. Synthetic paper from plastic waste: The effect of CaCO3 on physical, surface properties and printability. In Macromolecular Symposia; Wiley: Weinheim, Germany, 2006; Volume 245, pp. 611–620. [Google Scholar]
- Attaran, S.A.; Hassan, A.; Wahit, M.U. Materials for food packaging applications based on bio-based polymer nanocomposites: A review. J. Thermoplast. Compos. Mater. 2017, 30, 143–173. [Google Scholar] [CrossRef]
- Koven, S. They call us and we go. New Engl. J. Med. 2020, 382, 1978–1979. [Google Scholar] [CrossRef]
- Letko, M.; Marzi, A.; Munster, V. Functional assessment of cell entry and receptor usage for SARS-CoV-2 and other lineage B betacoronaviruses. Nat. Microbiol. 2020, 5, 562–569. [Google Scholar] [CrossRef] [PubMed]
- Johnson, N.P.; Mueller, J. Updating the accounts: Global mortality of the 1918-1920” Spanish” influenza pandemic. Bull. Hist. Med. 2002, 76, 105–115. [Google Scholar] [CrossRef] [PubMed]
- Patterson, K.D.; Pyle, G.F. The geography and mortality of the 1918 influenza pandemic. Bull. Hist. Med. 1991, 65, 4–21. [Google Scholar]
- Vasickova, P.; Pavlik, I.; Verani, M.; Carducci, A. Issues concerning survival of viruses on surfaces. Food Environ. Virol. 2010, 2, 24–34. [Google Scholar] [CrossRef]
- Das Jana, I.; Kumbhakar, P.; Banerjee, S.; Gowda, C.C.; Kedia, N.; Kuila, S.K.; Banerjee, S.; Das, N.C.; Das, A.K.; Manna, I. Copper Nanoparticle–Graphene Composite-Based Transparent Surface Coating with Antiviral Activity against Influenza Virus. ACS Appl. Nano Mater. 2020, 4, 352–362. [Google Scholar] [CrossRef]
- Huang, H.; Fan, C.; Li, M.; Nie, H.-L.; Wang, F.-B.; Wang, H.; Wang, R.; Xia, J.; Zheng, X.; Zuo, X. COVID-19: A call for physical scientists and engineers. ACS Nano 2020, 14, 3747–3754. [Google Scholar] [CrossRef]
- Minoshima, M.; Lu, Y.; Kimura, T.; Nakano, R.; Ishiguro, H.; Kubota, Y.; Hashimoto, K.; Sunada, K. Comparison of the antiviral effect of solid-state copper and silver compounds. J. Hazard. Mater. 2016, 312, 1–7. [Google Scholar] [CrossRef]
- Turner, R.J. Metal-based antimicrobial strategies. Microb. Biotechnol. 2017, 10, 1062–1065. [Google Scholar] [CrossRef]
- Olmos, D.; González-Benito, J. Polymeric materials with antibacterial activity: A Review. Polymers 2021, 13, 613. [Google Scholar] [CrossRef] [PubMed]
- Sunada, K.; Minoshima, M.; Hashimoto, K. Highly efficient antiviral and antibacterial activities of solid-state cuprous compounds. J. Hazard. Mater. 2012, 235, 265–270. [Google Scholar] [CrossRef]
- Hang, X.; Peng, H.; Song, H.; Qi, Z.; Miao, X.; Xu, W. Antiviral activity of cuprous oxide nanoparticles against Hepatitis C Virus in vitro. J. Virol. Methods 2015, 222, 150–157. [Google Scholar] [CrossRef] [PubMed]
- Lin, Y.E.; Stout, J.E.; Victor, L.Y. Controlling Legionella in hospital drinking water: An evidence-based review of disinfection methods. Infect. Control Hosp. Epidemiol. 2011, 32, 166–173. [Google Scholar] [CrossRef] [PubMed]
- Boonkaew, B.; Kempf, M.; Kimble, R.; Supaphol, P.; Cuttle, L. Antimicrobial efficacy of a novel silver hydrogel dressing compared to two common silver burn wound dressings: Acticoat™ and PolyMem Silver®. Burns 2014, 40, 89–96. [Google Scholar] [CrossRef] [PubMed]
- Zhang, A.; Wang, W.; Chai, Z.; Kuraoka, E. Modification of a novel macroporous silica-based crown ether impregnated polymeric composite with 1-dodecanol and its adsorption for some fission and non-fission products contained in high level liquid waste. Eur. Polym. J. 2008, 44, 3899–3907. [Google Scholar] [CrossRef]
- Ma, J.; Zhang, J.; Xiong, Z.; Yong, Y.; Zhao, X. Preparation, characterization and antibacterial properties of silver-modified graphene oxide. J. Mater. Chem. 2011, 21, 3350–3352. [Google Scholar] [CrossRef]
- Godoy-Gallardo, M.; Eckhard, U.; Delgado, L.M.; de Roo Puente, Y.J.; Hoyos-Nogués, M.; Gil, F.J.; Perez, R.A. Antibacterial approaches in tissue engineering using metal ions and nanoparticles: From mechanisms to applications. Bioact. Mater. 2021, 6, 4470–4490. [Google Scholar] [CrossRef]
- Perdikaki, A.; Galeou, A.; Pilatos, G.; Prombona, A.; Karanikolos, G.N. Ion-based metal/graphene antibacterial agents comprising mono-ionic and bi-ionic silver and copper species. Langmuir 2018, 34, 11156–11166. [Google Scholar] [CrossRef]
- Ahmed, W.; Siraj, S.; Al-Marzouqi, A.H. 3d printing pla waste to produce ceramic based particulate reinforced composite using abundant silica-sand: Mechanical properties characterization. Polymers 2020, 12, 2579. [Google Scholar] [CrossRef]
- Lee, D.W.; Yoo, B.R. Advanced silica/polymer composites: Materials and applications. J. Ind. Eng. Chem. 2016, 38, 1–12. [Google Scholar] [CrossRef]
- Ahmed, W.K.; Al-Douri, Y. Three-dimensional printing of ceramic powder technology. Met. Oxide Powder Technol. 2020, CH17, 351–383. [Google Scholar]
- Hakim, R.; Cailloux, J.; Santana, O.; Bou, J.; Sánchez-Soto, M.; Odent, J.; Raquez, J.-M.; Dubois, P.; Carrasco, F.; Maspoch, M.L. PLA/SiO2 composites: Influence of the filler modifications on the morphology, crystallization behavior, and mechanical properties. J. Appl. Polym. Sci. 2017, 134, 45367. [Google Scholar] [CrossRef]
- Jong, L. Synergistic effect of calcium carbonate and biobased particles for rubber reinforcement and comparison to silica reinforced rubber. J. Compos. Sci. 2020, 4, 113. [Google Scholar] [CrossRef]
- Agüero, Á.; Garcia-Sanoguera, D.; Lascano, D.; Rojas-Lema, S.; Ivorra-Martinez, J.; Fenollar, O.; Torres-Giner, S. Evaluation of different compatibilization strategies to improve the performance of injection-molded green composite pieces made of polylactide reinforced with short flaxseed fibers. Polymers 2020, 12, 821. [Google Scholar] [CrossRef] [PubMed]
- Benito, J.; Rios, G.; Ortea, E.; Fernández, E.; Cambiella, A.; Pazos, C.; Coca, J. Design and construction of a modular pilot plant for the treatment of oil-containing wastewaters. Desalination 2002, 147, 5–10. [Google Scholar] [CrossRef]
- Ahmed, W.; Siraj, S.; Al-Marzouqi, A.H. Embracing Additive Manufacturing Technology through Fused Filament Fabrication for Antimicrobial with Enhanced Formulated Materials. Polymers 2021, 13, 1523. [Google Scholar] [CrossRef]
- Vidakis, N.; Petousis, M.; Michailidis, N.; Grammatikos, S.; David, C.N.; Mountakis, N.; Argyros, A.; Boura, O. Development and Optimization of Medical-Grade Multi-Functional Polyamide 12-Cuprous Oxide Nanocomposites with Superior Mechanical and Antibacterial Properties for Cost-Effective 3D Printing. Nanomaterials 2022, 12, 534. [Google Scholar] [CrossRef]
- Eshkalak, S.K.; Ghomi, E.R.; Dai, Y.; Choudhury, D.; Ramakrishna, S. The role of three-dimensional printing in healthcare and medicine. Mater. Des. 2020, 194, 108940. [Google Scholar] [CrossRef]
- Zare, M.; Ghomi, E.R.; Venkatraman, P.D.; Ramakrishna, S. Silicone-based biomaterials for biomedical applications: Antimicrobial strategies and 3D printing technologies. J. Appl. Polym. Sci. 2021, 138, 50969. [Google Scholar] [CrossRef]
- Furka, S.; Furka, D.; Dadi, N.C.T.C.T.; Palacka, P.; Hromníková, D.; Santana, J.A.D.; Pineda, J.D.; Casas, S.D.; Bujdak, J. Novel antimicrobial materials designed for the 3D printing of medical devices used during the COVID-19 crisis. Rapid Prototyp. J. 2021, 27, 890–904. [Google Scholar] [CrossRef]
- Maróti, P.; Kocsis, B.; Ferencz, A.; Nyitrai, M.; Lőrinczy, D. Differential thermal analysis of the antibacterial effect of PLA-based materials planned for 3D printing. J. Therm. Anal. Calorim. 2020, 139, 367–374. [Google Scholar] [CrossRef]
- Tümer, E.H.; Erbil, H.Y. Extrusion-Based 3D printing applications of PLA composites: A review. Coatings 2021, 11, 390. [Google Scholar] [CrossRef]
- Wickramasinghe, S.; Do, T.; Tran, P. FDM-based 3D printing of polymer and associated composite: A review on mechanical properties, defects and treatments. Polymers 2020, 12, 1529. [Google Scholar] [CrossRef] [PubMed]
- Vidakis, N.; Petousis, M.; Velidakis, E.; Mountakis, N.; Tsikritzis, D.; Gkagkanatsiou, A.; Kanellopoulou, S. Investigation of the Biocidal Performance of Multi-Functional Resin/Copper Nanocomposites with Superior Mechanical Response in SLA 3D Printing. Biomimetics 2022, 7, 8. [Google Scholar] [CrossRef]
- Vidakis, N.; Petousis, M.; Velidakis, E.; Liebscher, M.; Tzounis, L. Three-dimensional printed antimicrobial objects of polylactic acid (PLA)-silver nanoparticle nanocomposite filaments produced by an in-situ reduction reactive melt mixing process. Biomimetics 2020, 5, 42. [Google Scholar] [CrossRef]
- Yang, F.; Zeng, J.; Long, H.; Xiao, J.; Luo, Y.; Gu, J.; Zhou, W.; Wei, Y.; Dong, X. Micrometer copper-zinc alloy particles-reinforced wood plastic composites with high gloss and antibacterial properties for 3D printing. Polymers 2020, 12, 621. [Google Scholar] [CrossRef]
- Vidakis, N.; Petousis, M.; Velidakis, E.; Mountakis, N.; Tzounis, L.; Liebscher, M.; Grammatikos, S.A. Enhanced mechanical, thermal and antimicrobial properties of additively manufactured polylactic acid with optimized nano silica content. Nanomaterials 2021, 11, 1012. [Google Scholar] [CrossRef]
- Jamnongkan, T.; Jaroensuk, O.; Khankhuean, A.; Laobuthee, A.; Srisawat, N.; Pangon, A.; Mongkholrattanasit, R.; Phuengphai, P.; Wattanakornsiri, A.; Huang, C.-F. A Comprehensive Evaluation of Mechanical, Thermal, and Antibacterial Properties of PLA/ZnO Nanoflower Biocomposite Filaments for 3D Printing Application. Polymers 2022, 14, 600. [Google Scholar] [CrossRef]
- Muwaffak, Z.; Goyanes, A.; Clark, V.; Basit, A.W.; Hilton, S.T.; Gaisford, S. Patient-specific 3D scanned and 3D printed antimicrobial polycaprolactone wound dressings. Int. J. Pharm. 2017, 527, 161–170. [Google Scholar] [CrossRef]
- Novak, J.I.; Loy, J. A critical review of initial 3D printed products responding to COVID-19 health and supply chain challenges. Emerald Open Res. 2020, 2, 24. [Google Scholar] [CrossRef]
- Longhitano, G.A.; Nunes, G.B.; Candido, G.; da Silva, J.V.L. The role of 3D printing during COVID-19 pandemic: A review. Prog. Addit. Manuf. 2021, 6, 19–37. [Google Scholar] [CrossRef]
- Zuniga, J.M.; Carson, A.M.; Peck, J.M.; Kalina, T.; Srivastava, R.M.; Peck, K. The development of a low-cost three-dimensional printed shoulder, arm, and hand prostheses for children. Prosthet. Orthot. Int. 2017, 41, 205–209. [Google Scholar] [CrossRef] [PubMed]
- Young, K.J.; Pierce, J.E.; Zuniga, J.M. Assessment of body-powered 3D printed partial finger prostheses: A case study. 3D Print. Med. 2019, 5, 7. [Google Scholar] [CrossRef]
- Perez-Gavilan, A.; de Castro, J.V.; Arana, A.; Merino, S.; Retolaza, A.; Alves, S.A.; Francone, A.; Kehagias, N.; Sotomayor-Torres, C.M.; Cocina, D. Antibacterial activity testing methods for hydrophobic patterned surfaces. Sci. Rep. 2021, 11, 6675. [Google Scholar] [CrossRef]
- Campden & Chorleywood Food Research Association. Manual of Microbiological Methods for the Food and Drink Industry; Campden & Chorleywood Food Research Association: Chipping Campden, UK, 2007. [Google Scholar]
- Maślana, K.; Żywicka, A.; Wenelska, K.; Mijowska, E. Boosting of antibacterial performance of cellulose based paper sheet via TiO2 nanoparticles. Int. J. Mol. Sci. 2021, 22, 1451. [Google Scholar] [CrossRef]
- Alvarez, E.; Uslan, D.Z.; Malloy, T.; Sinsheimer, P.; Godwin, H. It is time to revise our approach to registering antimicrobial agents for health care settings. Am. J. Infect. Control 2016, 44, 228–232. [Google Scholar] [CrossRef]
- Caires, C.S.; Farias, L.A.; Gomes, L.E.; Pinto, B.P.; Gonçalves, D.A.; Zagonel, L.F.; Nascimento, V.A.; Alves, D.C.; Colbeck, I.; Whitby, C. Effective killing of bacteria under blue-light irradiation promoted by green synthesized silver nanoparticles loaded on reduced graphene oxide sheets. Mater. Sci. Eng. C 2020, 113, 110984. [Google Scholar] [CrossRef]
- Goda, E.S.; Elella, M.H.A.; Sohail, M.; Singu, B.S.; Pandit, B.; El Shafey, A.; Aboraia, A.M.; Gamal, H.; Hong, S.E.; Yoon, K.R. N-methylene phosphonic acid chitosan/graphene sheets decorated with silver nanoparticles as green antimicrobial agents. Int. J. Biol. Macromol. 2021, 182, 680–688. [Google Scholar] [CrossRef]
- Wei, F.; Li, J.; Dong, C.; Bi, Y.; Han, X. Plasmonic Ag decorated graphitic carbon nitride sheets with enhanced visible-light response for photocatalytic water disinfection and organic pollutant removal. Chemosphere 2020, 242, 125201. [Google Scholar] [CrossRef]
- Alam, F.; Shukla, V.R.; Varadarajan, K.; Kumar, S. Microarchitected 3D printed polylactic acid (PLA) nanocomposite scaffolds for biomedical applications. J. Mech. Behav. Biomed. Mater. 2020, 103, 103576. [Google Scholar] [CrossRef] [PubMed]
- Badica, P.; Batalu, N.D.; Chifiriuc, M.C.; Burdusel, M.; Grigoroscuta, M.A.; Aldica, G.V.; Pasuk, I.; Kuncser, A.; Popa, M.; Agostino, A. Sintered and 3D-Printed Bulks of MgB2-Based Materials with Antimicrobial Properties. Molecules 2021, 26, 6045. [Google Scholar] [CrossRef] [PubMed]
- Du, X.; Shi, L.; Pang, J.; Zheng, H.; Shi, J.; Zhang, M. Fabrication of superwetting and antimicrobial wood-based mesoporous composite decorated with silver nanoparticles for purifying the polluted-water with oils, dyes and bacteria. J. Environ. Chem. Eng. 2022, 10, 107152. [Google Scholar] [CrossRef]
- Pandey, M.; Wasnik, K.; Gupta, S.; Singh, M.; Patra, S.; Gupta, P.; Pareek, D.; Maity, S.; Tilak, R.; Paik, P. Targeted specific inhibition of bacterial and Candida species by mesoporous Ag/Sn–SnO 2 composite nanoparticles: In silico and in vitro investigation. RSC Adv. 2022, 12, 1105–1120. [Google Scholar] [CrossRef] [PubMed]
- Nong, W.; Chen, Y.; Lv, D.; Yan, Y.; Zheng, X.; Shi, X.; Xu, Z.; Guan, W.; Wu, J.; Guan, Y. Metal-organic framework based nanozyme hybrid for synergistic bacterial eradication by lysozyme and light-triggered carvacrol release. Chem. Eng. J. 2022, 431, 134003. [Google Scholar] [CrossRef]
- Lou, G.; Chen, Y.; Xu, J.; Qian, Y.; Cheng, H.; Wei, Z.; Yang, Y.; Shen, L.; Shuai, C. Preparation of Graphene Oxide-loaded Nickel with Excellent Antibacterial Property by Magnetic Field-Assisted Scanning Jet Electrodeposition. Int. J. Bioprinting 2022, 8, 432. [Google Scholar] [CrossRef] [PubMed]
- Wang, L.; Hu, C.; Shao, L. The antimicrobial activity of nanoparticles: Present situation and prospects for the future. Int. J. Nanomed. 2017, 12, 1227. [Google Scholar] [CrossRef]
- Rajeshkumar, S.; Malarkodi, C.; Vanaja, M.; Annadurai, G. Anticancer and enhanced antimicrobial activity of biosynthesizd silver nanoparticles against clinical pathogens. J. Mol. Struct. 2016, 1116, 165–173. [Google Scholar] [CrossRef]
- Hamid, S.K.; Alghamdi, L.A.; Alshahrani, F.A.; Khan, S.Q.; Matin, A.; Gad, M.M. In Vitro Assessment of Artificial Aging on the Antifungal Activity of PMMA Denture Base Material Modified with ZrO2 Nanoparticles. Int. J. Dent. 2021, 2021, 5560443. [Google Scholar] [CrossRef]
- Ansari, A.; Siddiqui, V.U.; Rehman, W.U.; Akram, M.K.; Siddiqi, W.A.; Alosaimi, A.M.; Hussein, M.A.; Rafatullah, M. Green Synthesis of TiO2 Nanoparticles Using Acorus calamus Leaf Extract and Evaluating Its Photocatalytic and In Vitro Antimicrobial Activity. Catalysts 2022, 12, 181. [Google Scholar] [CrossRef]
- Ghanem, A.F.; Yassin, M.A.; Rabie, A.M.; Gouanvé, F.; Espuche, E.; Abdel Rehim, M.H. Investigation of water sorption, gas barrier and antimicrobial properties of polycaprolactone films contain modified graphene. J. Mater. Sci. 2021, 56, 497–512. [Google Scholar] [CrossRef]
- Wang, Y.; Li, Z.; Yang, D.; Qiu, X.; Xie, Y.; Zhang, X. Microwave-mediated fabrication of silver nanoparticles incorporated lignin-based composites with enhanced antibacterial activity via electrostatic capture effect. J. Colloid Interface Sci. 2021, 583, 80–88. [Google Scholar] [CrossRef] [PubMed]
- Benigno, E.; Lorente, M.; Olmosm, D.; González-Gaitano, G.; González-Benito, J. Nanocomposites based on LDPE filled with carbon nanotubes prepared by high energy ball milling and its potential anti-bacterial activity. Polym. Int. 2020, 68, 1155–1163. [Google Scholar] [CrossRef]
- Arriagada, P.; Palza, H.; Palma, P.; Flores, M.; Caviedes, P. Poly (lactic acid) composites based on graphene oxide particles with antibacterial behavior enhanced by electrical stimulus and biocompatibility. J. Biomed. Mater. Res. Part A 2018, 106, 1051–1060. [Google Scholar] [CrossRef]
- Maruthapandi, M.; Nagvenkar, A.P.; Perelshtein, I.; Gedanken, A. Carbon-dot initiated synthesis of polypyrrole and polypyrrole@ CuO micro/nanoparticles with enhanced antibacterial activity. ACS Appl. Polym. Mater. 2019, 1, 1181–1186. [Google Scholar] [CrossRef]
- Xu, Y.; Ma, J.; Han, Y.; Xu, H.; Wang, Y.; Qi, D.; Wang, W. A simple and universal strategy to deposit Ag/polypyrrole on various substrates for enhanced interfacial solar evaporation and antibacterial activity. Chem. Eng. J. 2020, 384, 123379. [Google Scholar] [CrossRef]
- Maruthapandi, M.; Saravanan, A.; Luong, J.H.; Gedanken, A. Antimicrobial properties of the polyaniline composites against Pseudomonas aeruginosa and Klebsiella pneumoniae. J. Funct. Biomater. 2020, 11, 59. [Google Scholar] [CrossRef]
- Boomi, P.; Poorani, G.P.; Palanisamy, S.; Selvam, S.; Ramanathan, G.; Ravikumar, S.; Barabadi, H.; Prabu, H.G.; Jeyakanthan, J.; Saravanan, M. Evaluation of antibacterial and anticancer potential of polyaniline-bimetal nanocomposites synthesized from chemical reduction method. J. Clust. Sci. 2019, 30, 715–726. [Google Scholar] [CrossRef]
- Yang, Z.; Hao, X.; Chen, S.; Ma, Z.; Wang, W.; Wang, C.; Yue, L.; Sun, H.; Shao, Q.; Murugadoss, V. Long-term antibacterial stable reduced graphene oxide nanocomposites loaded with cuprous oxide nanoparticles. J. Colloid Interface Sci. 2019, 533, 13–23. [Google Scholar] [CrossRef]
- Lee, M.; Han, S.-I.; Kim, C.; Velumani, S.; Han, A.; Kassiba, A.H.; Castaneda, H. ZrO2/ZnO/TiO2 Nanocomposite Coatings on Stainless Steel for Improved Corrosion Resistance, Biocompatibility, and Antimicrobial Activity. ACS Appl. Mater. Interfaces 2022, 14, 13801–13811. [Google Scholar] [CrossRef]
- Krumdieck, S.P.; Boichot, R.; Gorthy, R.; Land, J.G.; Lay, S.; Gardecka, A.J.; Polson, M.I.; Wasa, A.; Aitken, J.E.; Heinemann, J.A. Nanostructured TiO2 anatase-rutile-carbon solid coating with visible light antimicrobial activity. Sci. Rep. 2019, 9, 1883. [Google Scholar] [CrossRef] [PubMed]
- Cao, P.; Li, W.-W.; Morris, A.R.; Horrocks, P.D.; Yuan, C.-Q.; Yang, Y. Investigation of the antibiofilm capacity of peptide-modified stainless steel. R. Soc. Open Sci. 2018, 5, 172165. [Google Scholar] [CrossRef] [PubMed]
- Cao, P.; Du, C.; He, X.; Zhang, C.; Yuan, C. Modification of a derived antimicrobial peptide on steel surface for marine bacterial resistance. Appl. Surf. Sci. 2020, 510, 145512. [Google Scholar] [CrossRef]
- Terry, S.; Fidan, I.; Tantawi, K. Preliminary investigation into metal-material extrusion. Prog. Addit. Manuf. 2021, 6, 133–141. [Google Scholar] [CrossRef]
- Riecker, S.; Clouse, J.; Studnitzky, T.; Andersen, O.; Kieback, B. Fused Deposition Modeling-Opportunities for Cheap Metal AM. World PM2016-AM-Deposition Technologies. 2016. Available online: https://www.ifam.fraunhofer.de/content/dam/ifam/en/documents/dd/WorldPM2016/Riecker_Fused%20Deposition%20Modeling%20%E2%80%93%20Opportunities%20For%20Cheap%20Metal%20AM.pdf (accessed on 31 July 2022).
- Gong, H.; Snelling, D.; Kardel, K.; Carrano, A. Comparison of stainless steel 316L parts made by FDM-and SLM-based additive manufacturing processes. Jom 2019, 71, 880–885. [Google Scholar] [CrossRef]
- Gante Lokesha Renukaradhya, K. Metal Filament 3D Printing of SS316L: Focusing on the Printing Process. Master’s Thesis, KTH Royal Institute of Technology, School of Industrial Engineering and Management, Stockholm, Germany, 2019. Available online: https://thevirtualfoundry.com/wp-content/uploads/2022/02/19-01-KTH-Royal-Institute-of-Technology-Experimental-Work-with-3D-Printing-of-SS316L-Metal-Filament-Karthikesh-Gante-Lokesha-Renukaradhya.pdf (accessed on 31 July 2022).
- Ebrahimi, N.D.; Ju, Y.S. Thermal conductivity of sintered copper samples prepared using 3D printing-compatible polymer composite filaments. Addit. Manuf. 2018, 24, 479–485. [Google Scholar]
- Lu, H. Preliminary Mechanical Characterization of the Low-Cost Metal 3D Printing; Tennessee Technological University: Cookeville, TN, USA, 2020. [Google Scholar]
- Sava, M.; Nagy, R.; Menyhardt, K. Characteristics of 3D Printable Bronze PLA-Based Filament Composites for Gaskets. Materials 2021, 14, 4770. [Google Scholar] [CrossRef]
- Ayeni, O. Sintering and Characterizations of 3D Printed Bronze Metal Filament; Purdue University Graduate School: West Lafayette, IN, USA, 2019. [Google Scholar]
- Wang, X.; Ye, X.; Zhang, L.; Shao, Y.; Zhou, X.; Lu, M.; Chu, C.; Xue, F.; Bai, J. Corrosion and antimicrobial behavior of stainless steel prepared by one-step electrodeposition of silver at the grain boundaries. Surf. Coat. Technol. 2022, 439, 128428. [Google Scholar] [CrossRef]
- Di Cerbo, A.; Mescola, A.; Rosace, G.; Stocchi, R.; Rossi, G.; Alessandrini, A.; Preziuso, S.; Scarano, A.; Rea, S.; Loschi, A.R. Antibacterial Effect of Stainless Steel Surfaces Treated with a Nanotechnological Coating Approved for Food Contact. Microorganisms 2021, 9, 248. [Google Scholar] [CrossRef]
- Shuai, W.; Zhijiang, L.; Chunguang, Y.; Minggang, S.; Ke, Y. Antibacterial performance of 17-4PH stainless steel. Chin. J. Mater. Res. 2014, 28, 15–22. [Google Scholar]
- Resnik, M.; Benčina, M.; Levičnik, E.; Rawat, N.; Iglič, A.; Junkar, I. Strategies for improving antimicrobial properties of stainless steel. Materials 2020, 13, 2944. [Google Scholar] [CrossRef] [PubMed]
- Kietzmann, J.; Pitt, L.; Berthon, P. Disruptions, decisions, and destinations: Enter the age of 3-D printing and additive manufacturing. Bus. Horiz. 2015, 58, 209–215. [Google Scholar] [CrossRef]
- Mousapour, M.; Salmi, M.; Klemettinen, L.; Partanen, J. Feasibility study of producing multi-metal parts by Fused Filament Fabrication (FFF) technique. J. Manuf. Processes 2021, 67, 438–446. [Google Scholar] [CrossRef]
- Cura, U. Ultimaker Cura: Powerful, Easy-to-Use 3D Printing Software. 2019. Available online: https://ultimaker.com/software/ultimaker-cura (accessed on 31 July 2022).
- Malki, F.; Touati, A. In vitro inhibitory potential of two synthesized fatty amides derivatives against some microbial pathogens. Nov. Res. Microbiol. J. 2019, 3, 281–285. [Google Scholar]
- Hoseinzadeh, E.; Makhdoumi, P.; Taha, P.; Hossini, H.; Pirsaheb, M.; Omid Rastegar, S.; Stelling, J. A review of available techniques for determination of nano-antimicrobials activity. Toxin Rev. 2017, 36, 18–32. [Google Scholar] [CrossRef]
- Fasihi, H.; Noshirvani, N.; Hashemi, M.; Fazilati, M.; Salavati, H.; Coma, V. Antioxidant and antimicrobial properties of carbohydrate-based films enriched with cinnamon essential oil by Pickering emulsion method. Food Packag. Shelf Life 2019, 19, 147–154. [Google Scholar] [CrossRef]
- Abu, T.M.; Zahan, K.A.; Rajaie, M.A.; Leong, C.R.; Ab Rashid, S.; Hamin, N.S.M.N.; Tan, W.N.; Tong, W.Y. Nanocellulose as drug delivery system for honey as antimicrobial wound dressing. Mater. Today Proc. 2020, 31, 14–17. [Google Scholar]
- Villanueva, M.E.; Diez, A.M.a.d.R.; González, J.A.; Párez, C.J.; Orrego, M.; Piehl, L.; Teves, S.; Copello, G.J. Antimicrobial activity of starch hydrogel incorporated with copper nanoparticles. ACS Appl. Mater. Interfaces 2016, 8, 16280–16288. [Google Scholar] [CrossRef]
- Tolba, S.; El Shatoury, E.H.; Abo AlNasr, N.M. Prevalence of carbapenem resistant acinetobacter baumannii (CRAB) in some Egyptian hospitals: Evaluation of the use of blaOXA-51-like gene as species specific marker for CRAB. Egypt. J. Bot. 2019, 59, 723–733. [Google Scholar] [CrossRef]
- Kahlmeter, G.; Giske, C.G.; Kirn, T.J.; Sharp, S.E. Point-counterpoint: Differences between the European Committee on Antimicrobial Susceptibility Testing and Clinical and Laboratory Standards Institute recommendations for reporting antimicrobial susceptibility results. J. Clin. Microbiol. 2019, 57, e01129-19. [Google Scholar] [CrossRef]
- Zhang, E.; Zhao, X.; Hu, J.; Wang, R.; Fu, S.; Qin, G. Antibacterial metals and alloys for potential biomedical implants. Bioact. Mater. 2021, 6, 2569–2612. [Google Scholar] [CrossRef] [PubMed]
- Humphries, R.; Campeau, S.; Davis, T.E.; Nagaro, K.J.; LaBombardi, V.J.; Franklin, S.; Heimbach, L.; Dwivedi, H.P. Multicenter evaluation of ceftazidime-avibactam susceptibility testing of Enterobacterales and Pseudomonas aeruginosa on the VITEK 2 system. J. Clin. Microbiol. 2021, 59, e01870-20. [Google Scholar] [CrossRef] [PubMed]
- Song, D.; Lei, Y. Mini-review: Recent advances in imaging-based rapid antibiotic susceptibility testing. Sens. Actuators Rep. 2021, 3, 100053. [Google Scholar] [CrossRef]
- Litvinov, V.; Makarova, M.; Galkina, K.; Khachaturiants, E.; Krasnova, M.; Guntupova, L.; Safonova, S. Drug susceptibility testing of slowly growing non-tuberculous mycobacteria using slomyco test-system. PLoS ONE 2018, 13, e0203108. [Google Scholar] [CrossRef]
- Zhang, J.; Jia, P.; Zhu, Y.; Zhang, G.; Xu, Y.; Yang, Q. Performance Evaluation of BD Phoenix NMIC-413 Antimicrobial Susceptibility Testing Panel for Imipenem, Meropenem, and Ertapenem Against Clinical Carbapenem-Resistant and Carbapenem-Susceptible Enterobacterales. Front. Med. 2021, 8, 467. [Google Scholar] [CrossRef]
- Saputra, N.A.; Trisatya, D.R.; Darmawan, S.; Wibisono, H.S.; Pari, G. Effect citronella oil against bacteria strains: Escherichia coli ATCC 10536, Staphylococcus aureus ATCC 6538 and Salmonella typhimurium ATCC 14028. In IOP Conference Series: Earth and Environmental Science; IOP Publishing: Bristol, UK, 2020; Volume 460, p. 012027. [Google Scholar]
- Kalgudi, R.; Tamimi, R.; Kyazze, G.; Keshavarz, T. Quorum quenchers affect the virulence regulation of non-mucoid, mucoid and heavily mucoid biofilms co-cultured on cell lines. Appl. Microbiol. Biotechnol. 2021, 105, 8853–8868. [Google Scholar] [CrossRef]
- Olateju, O.A.; Babalola, C.P.; Olubiyi, O.O.; Kotila, O.A.; Kwasi, D.A.; Oaikhena, A.O.; Okeke, I.N. Quinoline Antimalarials Increase the Antibacterial Activity of Ampicillin. Front. Microbiol. 2021, 12, 1245. [Google Scholar] [CrossRef]
- Stojiljkovic, J.; Trajchev, M.; Nakov, D.; Petrovska, M. Antibacterial activities of rosemary essential oils and their components against pathogenic bacteria. Adv. Cytol. Pathol. 2018, 3, 93–96. [Google Scholar] [CrossRef]
- Henry, E.J.; Bird, S.J.; Gowland, P.; Collins, M.; Cassella, J.P. Ferrocenyl chalcone derivatives as possible antimicrobial agents. J. Antibiot. 2020, 73, 299–308. [Google Scholar] [CrossRef]
- Moradi, M.; Kousheh, S.A.; Razavi, R.; Rasouli, Y.; Ghorbani, M.; Divsalar, E.; Tajik, H.; Guimarães, J.T.; Ibrahim, S.A. Review of microbiological methods for testing protein and carbohydrate-based antimicrobial food packaging. Trends Food Sci. Technol. 2021, 111, 595–609. [Google Scholar] [CrossRef]
- Villapún, V.M.; Dover, L.G.; Cross, A.; González, S. Antibacterial metallic touch surfaces. Materials 2016, 9, 736. [Google Scholar] [CrossRef] [PubMed]
- Chan, S.P.; Lim, D.S.; Armugam, A.; Yi, G.; Zhang, Y. Soft Surface Nanostructure with Semi-Free Polyionic Components for Sustainable Antimicrobial Plastic. Int. J. Mol. Sci. 2021, 22, 12315. [Google Scholar] [CrossRef] [PubMed]
- Calovi, M.; Furlan, B.; Coroneo, V.; Massidda, O.; Rossi, S. Facile Route to Effective Antimicrobial Aluminum Oxide Layer Realized by Co-Deposition with Silver Nitrate. Coatings 2022, 12, 28. [Google Scholar] [CrossRef]
- Al Zahmi, S.; Alhammadi, S.; ElHassan, A.; Ahmed, W. Carbon Fiber/PLA Recycled Composite. Polymers 2022, 14, 2194. [Google Scholar] [CrossRef]
- Al-Mazrouei, N.; Ismail, A.; Ahmed, W.; Al-Marzouqi, A.H. ABS/Silicon Dioxide Micro Particulate Composite from 3D Printing Polymeric Waste. Polymers 2022, 14, 509. [Google Scholar] [CrossRef] [PubMed]
- Al-Mazrouei, N.; Al-Marzouqi, A.H.; Ahmed, W. Characterization and Sustainability Potential of Recycling 3D-Printed Nylon Composite Wastes. Sustainability 2022, 14, 10458. [Google Scholar] [CrossRef]
- Ahmed, W.; Zaneldin, E.; Al Hassan, A.; Al-Marzouqi, A.H. Chapter 9: Nanomaterial Used in 3D Printing Technology. In Smart 3D Nanoprinting: Fundamentals, Materials, and Applications, 1st ed.; CRC Press: Boca Raton, FL, USA, 2022. [Google Scholar]

| Sample | Type of Bacteria | Inoculum | Bacterial Amount | |||||
|---|---|---|---|---|---|---|---|---|
| 5 min | 10 min | 20 min | 1 h | 8 h | 24 h | |||
| Control sheet | Escherichia coli | 9500 | 9296 | 9016 | 8680 | 7784 | 5432 | 2352 |
| Staphylococcus aureus | 5000 | 4536 | 4480 | 4200 | 3136 | 2520 | 9 | |
| Pseudomonas aeruginosa | 7500 | 7280 | 6944 | 6440 | 4074 | 2632 | 23 | |
| Salmonella Poona | 9000 | 8512 | 8456 | 8232 | 7168 | 1364 | 684 | |
| Enterococci | 5000 | 4312 | 4256 | 3976 | 3080 | 2968 | 89 | |
| Sample | Type of Bacteria | Inoculum | Bacterial Amount | |||||
|---|---|---|---|---|---|---|---|---|
| 5 min | 10 min | 20 min | 1 h | 8 h | 24 h | |||
| Sample 1 PLA/copper | Escherichia coli | 9500 | 162 | 149 | 25 | 1 | 1 | 1 |
| Staphylococcus aureus | 5000 | 2968 | 2296 | 1 | 1 | 1 | 1 | |
| Pseudomonas aeruginosa | 7500 | 203 | 189 | 1 | 1 | 1 | 1 | |
| Salmonella Poona | 9000 | 164 | 163 | 1 | 1 | 1 | 1 | |
| Enterococci | 5000 | 314 | 284 | 1 | 1 | 1 | 1 | |
| Sample | Type of Bacteria | Inoculum | Bacterial Amount | |||||
|---|---|---|---|---|---|---|---|---|
| 5 min | 10 min | 20 min | 1 h | 8 h | 24 h | |||
| Sample 2 PLA/Al | Escherichia coli | 9500 | 8848 | 8288 | 5320 | 4648 | 1 | 1 |
| Staphylococcus aureus | 5000 | 4032 | 3304 | 89 | 51 | 1 | 1 | |
| Pseudomonas aeruginosa | 7500 | 7392 | 7168 | 2464 | 2408 | 1 | 1 | |
| Salmonella Poona | 9000 | 8064 | 7784 | 492 | 388 | 1 | 1 | |
| Enterococci | 5000 | 3864 | 3528 | 1232 | 5 | 1 | 1 | |
| Sample | Type of Bacteria | Inoculum | Bacterial Amount | |||||
|---|---|---|---|---|---|---|---|---|
| 5 min | 10 min | 20 min | 1 h | 8 h | 24 h | |||
| Sample 3 PLA/bronze | Escherichia coli | 9500 | 3584 | 35 | 3 | 1 | 1 | 1 |
| Staphylococcus aureus | 5000 | 1696 | 304 | 9 | 1 | 1 | 1 | |
| Pseudomonas aeruginosa | 7500 | 15 | 1 | 1 | 1 | 1 | 1 | |
| Salmonella Poona | 9000 | 17 | 1 | 1 | 1 | 1 | 1 | |
| Enterococci | 5000 | 656 | 19 | 1 | 1 | 1 | 1 | |
| Sample | Type of Bacteria | Inoculum | Bacterial Amount | |||||
|---|---|---|---|---|---|---|---|---|
| 5 min | 10 min | 20 min | 1 h | 8 h | 24 h | |||
| Sample 4 PLA/stainless steel | Escherichia coli | 9500 | 8736 | 5936 | 4312 | 3192 | 1 | 1 |
| Staphylococcus aureus | 5000 | 2184 | 1624 | 280 | 28 | 1 | 1 | |
| Pseudomonas aeruginosa | 7500 | 4368 | 3080 | 2733 | 1288 | 1 | 1 | |
| Salmonella Poona | 9000 | 7392 | 6384 | 4928 | 4168 | 1 | 1 | |
| Enterococci | 5000 | 4256 | 3024 | 1120 | 5 | 1 | 1 | |
| Composites | Type of Bacteria | Killing Rate | Ref. |
|---|---|---|---|
| PLA/GO 5% | S. aureus, E. coli | 100% (24 h) for S. aureus and E. coli | [66] |
| PPY/CuO | S. aureus, E. coli | 100% (8 h) | [67] |
| Ag/PPY | S. aureus, E. coli | 92.6% (24 h) | [68] |
| SiO2/PANI | P. aeruginosa | 100% (12 h) | [69] |
| MWCNT/PANI | S. aureus, E. coli | 99.9% (24 h) | [70] |
| Cu2O/rGO | E. coli | 70% and 65% for 18 h | [71] |
| Stainless Steel coated with ZrO2/ZnO/TiO2 | S. aureus, E. coli | 81.2% and 72.4% after 12 h | [72] |
| Stainless steel doped with TiO2 | E. coli | 99.9% after 4 h under UV | [73] |
| Stainless steel modified with peptide | S. aureus, E. coli | 56.9% after 3 h | [74] |
| Stainless steel coated with derived antimicrobial peptide | V. natriegens and C. farmer (marine bacteria) | 99.79% and 99.33% after 24 h | [75] |
| PLA/copper | E. coli, S. aureus | 99.99% and 99.98% after 1 h | Present study |
| PLA/aluminum | E. coli, S. aureus | 99.99% (8 h) and 98.98% (1 h) | Present study |
| PLA/bronze | E. coli, S. aureus | 99.99% and 99.98% (1 h) | Present study |
| PLA/stainless steel | E. coli, S. aureus | 99.99% and 99.98% (8 h) | Present study |
Publisher’s Note: MDPI stays neutral with regard to jurisdictional claims in published maps and institutional affiliations. |
© 2022 by the authors. Licensee MDPI, Basel, Switzerland. This article is an open access article distributed under the terms and conditions of the Creative Commons Attribution (CC BY) license (https://creativecommons.org/licenses/by/4.0/).
Share and Cite
Ahmed, W.; Al-Marzouqi, A.H.; Nazir, M.H.; Rizvi, T.A.; Zaneldin, E.; Khan, M. Comparative Experimental Investigation of Biodegradable Antimicrobial Polymer-Based Composite Produced by 3D Printing Technology Enriched with Metallic Particles. Int. J. Mol. Sci. 2022, 23, 11235. https://doi.org/10.3390/ijms231911235
Ahmed W, Al-Marzouqi AH, Nazir MH, Rizvi TA, Zaneldin E, Khan M. Comparative Experimental Investigation of Biodegradable Antimicrobial Polymer-Based Composite Produced by 3D Printing Technology Enriched with Metallic Particles. International Journal of Molecular Sciences. 2022; 23(19):11235. https://doi.org/10.3390/ijms231911235
Chicago/Turabian StyleAhmed, Waleed, Ali H. Al-Marzouqi, Muhammad Hamza Nazir, Tahir A. Rizvi, Essam Zaneldin, and Mushtaq Khan. 2022. "Comparative Experimental Investigation of Biodegradable Antimicrobial Polymer-Based Composite Produced by 3D Printing Technology Enriched with Metallic Particles" International Journal of Molecular Sciences 23, no. 19: 11235. https://doi.org/10.3390/ijms231911235
APA StyleAhmed, W., Al-Marzouqi, A. H., Nazir, M. H., Rizvi, T. A., Zaneldin, E., & Khan, M. (2022). Comparative Experimental Investigation of Biodegradable Antimicrobial Polymer-Based Composite Produced by 3D Printing Technology Enriched with Metallic Particles. International Journal of Molecular Sciences, 23(19), 11235. https://doi.org/10.3390/ijms231911235

